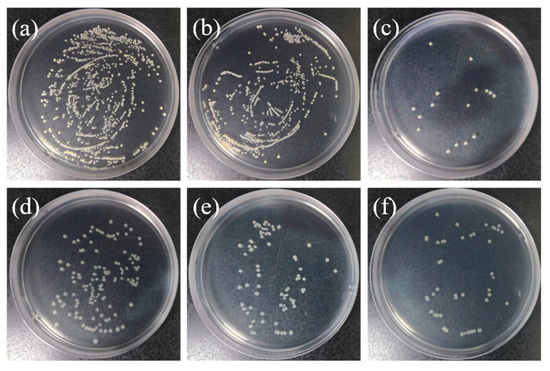

Abstract
Titanium (Ti), as a hard tissue implant, is facing a big challenge for rapid and stable osseointegration owing to its intrinsic bio-inertness. Meanwile, surface-related infection is also a serious threat. In this study, large-scale quasi-vertically aligned sodium titanate nanowire (SNW) arrayed coatings incorporated with bioactive Cu2+ ions were fabricated through a compound process involving acid etching, hydrothermal treatment (HT), and ion exchange (IE). A novel coating based on sustained ion release and a shape-preserving design is successfully obtained. Cu2+ substituted Na+ in sodium titanate lattice to generate Cu-doped SNW (CNW), which maintains the micro-structure and phase components of the original SNW, and can be efficiently released from the structure by immersing them in physiological saline (PS) solutions, ensuring superior long-term structural stability. The synergistic effects of the acid etching, bidirectional cogrowth, and solution-strengthening mechanisms endow the coating with higher bonding strengths. In vitro antibacterial tests demonstrated that the CNW coatings exhibited effective good antibacterial properties against both Gram-positive and Gram-negative bacteria based on the continuous slow release of copper ions. This is an exciting attempt to achieve topographic, hydrophilic, and antibacterial activation of metal implants, demonstrating a paradigm for the activation of coatings without dissolution and providing new insights into insoluble ceramic-coated implants with high bonding strengths.
1. Introduction
Titanium and its alloys are used in the repair and replacement of human hard tissue and have become the preferred metal materials for replacement or repair products such as artificial joints, artificial bones, and broken bone fixators. However, as bioinert material titanium can easily encapsulate fibrous tissue in the early stages of implantation, this makes it difficult to form a firm osseous bond with the host bone [1]. Currently, the application of implant materials is mainly limited by the lack of proper interaction between the materials and bone tissue, which is characterized by the difficulty of bone integration and the serious shortening of the service life of implants [2].
Studies have shown that the interface between the tissue and the implant material is a key factor in determining the effect of bone integration. As the most important aspect of bone implants, this interface can enhance the functional activities of osteoblasts, inducing solid contact between the implants and bone tissue without fibrous connective tissue [3]. The main parameters that determine the interface properties of tissue and implant materials include the chemical composition of the implant surface [4,5,6], surface energy or hydrophilicity [4,7], roughness [8,9], surface morphology [4,10,11,12,13], and mechanical properties of the coating [14]. Nanofiber scaffolds with three-dimensional structures have attracted increasing attention because they more closely resemble the natural cell-growth microenvironment [15,16]. The surface topology of nanofiber coatings can promote the exploration, sensing, and migration of cells, enabling more actin cytoskeleton fibers to be synthesized into platelike pseudopods, and form a firm bond with the material surface [17,18,19]. The surface of a nanofiber network absorbs four times more serum proteins than the smooth surface and enhances the adhesion of cells [20], which reflects the high biological activity of the nanofiber network. Therefore, bioactivation modification on titanium metal is the key to improving the repair and replacement of hard tissue.
Although biomimetic coatings can be obtained by gel–sol, magnetron sputtering, micro-arc oxidation, vapor deposition, and plasma spraying, these coatings are neither nanofiber forms nor can they be firmly bonded to the matrix [21,22]. Wear and spalling occur in the process of implantation owing to poor binding, and aseptic loosening is further caused by tiny particles produced by spalling.
Currently, many implants constructed with surface topological configurations dissolve and collapse during physical/chemical reactions with the surrounding microenvironment after implantation, which does not guarantee the subsequent regulation of cell behavior [23,24]. To resolve the conflict between early osseointegration and long-term fixation of soluble ceramic-coated implants to bone, persistent efforts to seek alternative strategies to dissolution-derived activation are currently being conducted. In particular, nanostructured titania [25], titanate nanotubes [26], and nanofibers [27], all of which are insoluble, have been recently developed to act as hydrophilic and topographic activators of Ti implants, creating a paradigm for activation without the dissolution of coatings.
It is increasingly recognized that an ideal bone integration process also requires good neovascularization, which not only provides nutrition supply for new bone formation, but also promotes the remote homing of bone-marrow-derived stem cells (MSCs) to the implant surface to form bone [28]. Copper is an essential trace element in the human body that participates in various metabolic processes [29]. Meanwhile, copper ions can promote angiogenesis and osteogenesis [30,31,32], accelerate the early healing of skin wounds [33,34,35], and exhibit good antibacterial properties by inactivating bacterial central catabolism and biosynthesis modes [31,32,35,36]. Compared with the antibacterial metal ions such as zinc and silver ions, copper ions show the best compromise between antibacterial action and cytotoxicity [32].
Herein, considering morphology bionics and inorganic active metal ion loading, we design and construct copper-doped titanate nanowires coatings (CNWs) with high binding strength and stability. Moreover, benefiting from the slow-release of Cu2+ ions, the obtained coatings exhibit superior antibacterial activity, against both Gram-positive and Gram-negative bacteria, indicating bright prospects in biomedical implant applications.
2. Materials and Methods
2.1. Preparation and Cu2+ Ionic Incorporation in SNW Coatings
First of all, the commercial pure titanium rod (purity of 99.5 wt%) is processed into titanium sheets (φ14 × 2 mm) and then polished with 320–1500 metallographic sandpaper in turn, and finally mechanical polishing with diamond grinding paste to achieve the mirror bright effect [26]. The pitting surface was obtained by etching the mechanical polished Ti disks (P-Ti) for 25 s at room temperature to remove surface oxides and dirt. The etching solution consisted of 1:1:8 nitric acid (HNO3, 69.2%; Sinopharm Chemical Reagent Co., Ltd., Shanghai, China), hydrofluoric acid (HF, 40%; Sinopharm Chemical Reagent Co., Ltd., Shanghai, China), and deionized water. The acid-etched Ti disks (A-Ti) were ultrasonically cleaned in acetone, ethanol, and distilled water and dried in an ambient atmosphere. For the topographical SNW growth, each A-Ti disk was hydrothermally treated in 20 mL 1 M aqueous NaOH (Sinopharm Chemical Reagent Co., Ltd., Shanghai, China) at 220 °C for 2.5 h. After the reaction vessel cooled to room temperature, the obtained SNW-coated A-Ti (referred to as SNW/A-Ti) disks were removed and hydrothermally treated in 20 mL 1 mM aqueous CuCl2·2H2O (Sinopharm Chemical Reagent Co., Ltd., Shanghai, China) at 150 °C for 2 h for Cu2+ ion incorporation. The resulting samples are referred to as CNW/A-Ti.
2.2. Structural Characterization of the Coatings
The morphologies of the samples including surface and cross-section were observed using field-emission scanning electron microscopy (MERLIN COMPACT, Carl Zeiss AG, Cambridge, UK). From these, ImageJ software (v 1.37c, National Institutes of Health, Bethesda, MD, USA) was used to examine the nanowire diameter and length. Five random areas were measured to obtain average values. The elemental compositions of the samples were examined by energy-dispersive X-ray spectrometry (X-MamN, Oxford, UK). X-ray diffractometry (X’Pert PRO, PANalytical Co., Almelo, The Netherland) was used to identify phasic components. (Cu-Kα, 20–55°, 40 kV, a scanning speed of 3° min−1 and an incident angle of 1°). X-ray photoelectron spectroscopy (K-Alpha, Thermo Scientific, Waltham, MA, USA) was used to detect the chemical species on the surfaces of the coatings (Al-Kα and a photoelectron takeoff angle of 45°). The binding energy of 284.8 eV (C 1s) was used to calibrate the XPS spectra obtained. The atomic force microscopy (SPM-9500J3, Shimadzu, Kyoto, Japan) was used to perform surface roughness measurements. Five random areas were measured to obtain average values.
2.3. Bonding Strengths of the Coatings
To identify the adhesive strengths of the coatings on the Ti discs, scratch tests were performed using an auto-scratch coating tester (WS-2006, Zhongke Kaihua Technology Development Co., Ltd., Lanzhou, China) that consisted of a spherical stylus [37]. According to the set loading rate and scratch speed, the computer control system starts continuous loading and translation of the measured sample at the same time. With the increasing load applied from the tip of the diamond cone to the surface of the sample and the continuous movement of the sample, the changing load value during the scratch process and the acoustic emission signal generated when the coating on the surface of the sample is damaged and spalling are automatically detected. The corresponding curve of acoustic emission signal and load change is shown. When the set load is reached, the test ends. The loading load is automatically unloaded to zero and the sample is returned to its original position. The load corresponding to the initial identifiable fault location is called the critical load (Lc). It is determined by acoustic emission signal and SEM microregion analysis of the scratches. Three samples were used for each coating type, and the critical loads were averaged.
2.4. Wettability of the Coatings
The hydrophilicity of the coatings can be expressed by the water contact angle, which was measured using a surface contact angle measurement machine (DSA30, Kruss, Berlin, Germany) [38]. Five samples were used for each coating type, and the measurements were averaged.
2.5. Cu2+ Released from the Coatings
The in vitro release of Cu2+ ions from the coatings was evaluated by immersing them in physiological saline (PS) solutions (e.g., 0.9 wt% aqueous NaCl) at 37 °C for 0, 1, 3, 7, 14, and 21 d, and then examining the changes in ion concentrations of the obtained solutions by inductively coupled plasma emission spectroscopy (ICAP 6300, Thermo Scientific, Waltham, MA, USA) [39]. At the same time, scanning electron microscopy was used to observe the surface and cross-section morphology of the immersion coating. Five specimens of each coating were used at each immersion time.
2.6. In Vitro Antibacterial Test
In the antibacterial test in vitro, Staphylococcus aureus (S. aureus ATCC25293, China General Microbiological Culture Collection Center) was used as Gram-positive bacteria model and Escherichia coli (E. coli ATCC25922, China General Microbiological Culture Collection Center) as Gram-negative bacteria model. The sample was placed in a 24-well plate, each well was injected with 1 mL bacterial solution at a concentration of 1 × 106 CFU·mL−1. The samples were washed at least 3 times in PBS after incubation at 37 °C for 24 h. The bacteria attached to the samples were separated in 1 mL PBS by ultrasonic vibration for 5 min [40]. The isolated bacteria were collected and inoculated into an agar culture medium. The viable bacteria were counted by the Chinese National Standard (GB/T 4789.2 [41]) after incubation at 37 °C for 24 h. The calculation formula of antibacterial rate is expressed as Ra (%) = (B − A)/B × 100%, where A and B are the number of viable bacteria on the coatings and A-Ti, respectively. Each test was repeated four times.
3. Results
3.1. Topography of the P-Ti before and after Acid Etching
The surface SEM and AFM images are shown in Figure 1 for P-Ti disks before and after acid etching. A homogeneous micro-pitted structure was produced on the titanium matrix of A-Ti by acid-etching that can also make the titanium matrix fully exposed, clean, and uniform. AFM images of the specimens are shown on the right-hand side of Figure 1. A rougher surface has a larger surface area, which is more conducive to cell adhesion, proliferation, and differentiation in vitro and early bone growth in vivo [32,42,43,44,45]. Based on a 40 × 40 μm2 scan area, P-Ti had a plain structure with Ra (average surface centerline roughness), Rq (root mean square roughness), and Rz (10-point height of irregularity roughness) values of 141.1 ± 7.4, 181.1 ± 4.7, and 1074.0 ± 97.0 nm, respectively. A-Ti exhibited a microdimple-patterned Ti surface with Ra, Rq, and Rz values of 205.9 ± 12.8, 256.3 ± 13.8, and 1180.9 ± 113.4 nm, respectively. This reveals that the surface characteristics of A-Ti are superior to those of P-Ti. The clean and simple reaction interface is not only conducive to the subsequent hydrothermal reaction but also to the high adhesion of the coatings on the Ti substrates. At the same time, the micro-pitted structure enables the coatings to be embedded with the substrate through the “rivet” effect, that is, to further increase the binding between the substrate and the coatings through mechanical embedment.

Figure 1.
Surface SEM and AFM images of (a) P-Ti and (b) A-Ti.
3.2. Structure and Topography of the HT Coatings before and after IE
Figure 2 shows the SEM and AFM images of SNW/A-Ti and CNW/A-Ti. The surface morphologies of all coatings exhibited well-ordered structures. The A-Ti discs after the reaction with alkaline under hydrothermal conditions are shown on the left of Figure 2a. Large-scale quasi-vertically aligned and top-flat SNW (diameter 54.2 ± 2.8 nm, length approximately 2.2 µm) formed uniformly on the A-Ti substrates. After hydrothermal IE with 0.001 M CuCl2 at 150 °C for 2 h, CNW with a diameter of 54.8 ± 1.7 nm and a length of approximately 2.1 µm formed, as shown on the left of Figure 2b. It can be observed that copper incorporation does not alter the main structural characteristics, including the nanowire morphology and size. According to the EDX results presented in the tables (inserted on the left images in Figure 2), Na, Ti, and O are present on the SNW/A-Ti surface, whereas, after IE, only Cu, Ti, and O are detected on the CNW/A-Ti surface, demonstrating the complete replacement of Na+ ions by Cu2+ ions. We achieved uniform incorporation of Cu2+ ions into the SNW throughout the entire length by analyzing cross-sectional SEM morphologies and EDX profiles as shown in Figure 2 (the center images). There was no apparent discontinuity between the coatings and the Ti substrates for either SNW/A-Ti or CNW/A-Ti, indicating that all the coatings were tightly bonded to the Ti substrates. From the AFM images (right side of Figure 2), SNW/A-Ti exhibited a dual-scale topography that appeared to be micro-concave with overlapping quasi-vertically aligned SNWs. The Ra, Rq, and Rz values of SNW/A-Ti were slightly greater than those of A-Ti. Moreover, the measured roughness values (Table 1) had no significant difference in between SNW/A-Ti and CNW/A-Ti. The similar nanowire topographies suggest that the incorporation of Cu into the sodium titanate did not significantly alter the surface topographical characteristics. Thus, the Na+ ions in the SNW could be thoroughly eliminated via a facile ion-exchange strategy with the desired Cu2+ ions, and the surface nanowire topography on the titanium substrate was simultaneously retained.

Figure 2.
Surface, cross-sectional SEM morphologies, and AFM images of the as-synthesized (a) SNW/A-Ti and (b) CNW/A-Ti.

Table 1.
Roughness values based on AFM analysis of P-Ti, A-Ti, SNW/A-Ti, and CNW/A-Ti.
3.3. Phases and Surface Chemical Species of the Coatings
The phase components of the samples were analyzed using an X-ray diffractometer, the XRD patterns detected are shown in Figure 3. The peaks (24.2°, 28.22°, 48.32°, and 49.52°) correspond to the crystallographic planes of Na2Ti6O13 phase (JCPDS no. 73-1398), which are (1 1 0), (3 1 0), (0 2 0), and (2 2 0), respectively. For CNW/A-Ti, none of the Cu-containing phases were detected. Compared with SNW/A-Ti, no obvious changes were observed in the phase components, only the peak positions were shifted slightly to higher angles. In the monoclinic Na2Ti6O13 lattice, the substitution of Cu2+ (0.72 Å) causes lattice contraction due to smaller ionic radius than Na+ (0.95 Å).

Figure 3.
XRD patterns of the coatings.
The surfaces of the coatings were analyzed using XPS to explore the chemical states of the elements. Figure 4a shows the full spectra of SNW/A-Ti and CNW/A-Ti, revealing that the high Na content in SNW/A-Ti decreased to nearly zero upon conversion to CNW/A-Ti via copper IE, with an associated increase in the Cu content. This result can also be drawn from the appearance of the peak at ~506.4 eV for SNW/A-Ti, which could be related to Na KLL Auger electrons. However, it is not detected in CNW/A-Ti.

Figure 4.
XPS spectra of the coatings: (a) full spectra, (b) Na 1s, (c) Cu 2p, (d) O 1s, and (e) Ti 2p.
The high-resolution XPS spectra of Na 1s, Cu 2p, O 1s, and Ti 2p are shown in Figure 4b–e, respectively. The Na 1s spectra of SNW/A-Ti and CNW/A-Ti (Figure 4b) show that the peaks at 1074.0 and 1069.3 eV could be related to two Ti LMM Auger electron peaks, respectively [46]. The peak at 1071.8 eV was assigned to Na+ (Na 1s) in SNW/A-Ti [47,48]. This peak was not detected for CNW/A-Ti.
In the Cu 2p spectra (Figure 4c), the peaks at 933.9 eV (Cu 2p3/2) and 953.7 eV (Cu 2p1/2), and the existence of the doublet shakeup satellites at 944.6 and 963.9 eV, respectively, indicate that Cu bonds with O and exists in divalent ion states in the CNW coatings [49]. The disappearance of the peak at 1071.8 eV (Na+ in the Na 1s spectra) and ~506.4 eV (Na KLL Auger electrons in the full spectra) and the existence of the characteristic peaks of Cu2+ indicate that Na+ ions were nearly completely replaced by Cu2+ during the IE reaction.
In the O 1s spectrum (Figure 4d), the peak at 530.7 eV for SNW/A-Ti, and 530.8 eV for CNW/A-Ti are corresponding to O atoms bound to metal atoms, respectively [50].
The Ti 2p spectra (Figure 4e) show four peaks for each sample. The peaks at 458.5 and 459.3 eV for SNW/A-Ti, and 458.6 and 459.8 eV for CNW/A-Ti could be attributed to Ti 2p3/2 Ti(Ⅲ) and Ti(Ⅳ), respectively. The peaks at 464.2 and 465.2 eV for SNW/A-Ti and 464.3 and 465.7 eV for CNW/A-Ti could be ascribed to Ti 2p1/2 Ti(Ⅲ) and Ti(Ⅳ), respectively [46,50,51]. Compared with the Cu-free sample, the CNW/A-Ti had a shift toward higher binding energies about 0.1–0.5 eV.
Na2Ti6O13 is composed of four TiO6 octahedral units that share edges on a single level. These units are combined with several similar units above and below through additional edge-sharing [52]. The presence of Cu2+ ions can replace the Na+ ions in the titanate layer via ion exchange (IE). After Cu doping, the Ti 2p peaks shift toward higher binding energies due to the electronic interaction between incorporated Cu2+ and TiO6 layers. Based on the combined results from EDS, XRD, and XPS analyses, successful Cu doping of CNW/A-Ti can be confirmed along with the existence of Cu in the form of Cu2+.
3.4. The Formation Mechanism of SNW/A-Ti and CNW/A-Ti
The formation mechanism of novel nanostructures on titanium metal can be explained by considering the simultaneous processes of dissolution, reprecipitation, and subsequent IE. According to the experimental results presented herein and the literature reported, the chemical reaction for the synthesis of the titanate ions () can be described by the following formula (Equations (1)–(3)). When pure titanium is placed in an alkali solution at high temperature and pressure, the hydroxyl group in solution will react with it (Reaction 1) [53,54]:
Therewith the hydrated titanium dioxide is obtained by (Reaction 2):
According to Reaction 3, the hydroxyl group will further attack the hydrated titanium dioxide to generate titanate ions () with negatively charged surfaces developing affinities for metal cations [55]:
The anions formed in the dissolution step react with Na+ cations in an alkaline solution to form Na2Ti6O13 [56,57,58,59]. This precipitation reaction can be represented as:
After immersion in an aqueous CuCl2 solution, the Cu2+ ions with a smaller radius than Na+ ions could more easily diffuse into the inter-lattice space (7.466 Å) of the Na2Ti6O13 coating, replacing the latter.
Compared to the SNW, the incorporation of Cu2+ ions increases lattice distortion and decreases interplanar distances. However, the surface morphology and phase of the CNW remain unchanged.
3.5. Hydrophilicity of Coatings
The hydrophilicity of hard-tissue implants is crucial for osteointegration in the biological tissue response usually indicated by the water contact angle. Figure 5 shows the images of water droplets on P-Ti, A-Ti, SNW/A-Ti, and CNW/A-Ti; the corresponding contact angles are 95.7 ± 1.15°, 57.3 ± 0.16°, 8.2 ± 1.12°, and 14.3 ± 0.76°, respectively. Acid etching and further arraying with SNWs improved the surface energies and, thus, the hydrophilicities of A-Ti and SNW/A-Ti compared to those of P-Ti. Although there was no significant difference in the surface topographical characteristics of SNW/A-Ti and CNW/A-Ti, according to the structural analysis described above, the contact angles of CNW/A-Ti were slightly greater than those of SNW/A-Ti.

Figure 5.
Water contact angle images of (a) P-Ti, (b) A-Ti, (c) SNW/A-Ti, and (d) CNW/A-Ti.
3.6. Bonding Integrity of the Coatings
We used a scratch test to characterize the bond strength of a coating by the critical load (Lc), depending on the failure occurring at the coating/substrate interface or in the interior of the coating under this load. The acoustic output vs. load curves and scratch morphologies of the coatings are shown in Figure 6. The initially delaminating areas occurred in the interiors of the coatings, indicating that the critical loads characterized the cohesive strengths of the coatings and that the adhesive strengths between the coatings and substrates were higher than the Lc values. This is supported by the fact that the SNW-traced Na and the CNW-traced Cu could still be detected by EDX in the delaminating region, where the Na and Cu contents were far lower than those detected on the unscratched coating surfaces (listed on the right of Figure 6). As shown on the left of Figure 6, the cohesive strengths of SNW/A-Ti and CNW/A-Ti are 48.5 ± 0.48 and 52.6 ± 0.53 N, respectively, indicating a strong binding of the coatings to the substrates.

Figure 6.
Curves of acoustic output versus load and scratch morphologies of (a) SNW/A-Ti and (b) CNW/A-Ti, including magnified views of initially delaminating areas along with EDX values detected on the ①—marked nanowires and ②—marked delaminating region.
This exciting bond strength of titanate coatings has not been previously achieved [60,61,62,63] and may be due to the contribution of three mechanisms: acid etching, bidirectional cogrowth, and solution strengthening. As discussed in Section 3.1, before the HT, an acid etching process was implemented, which further removed dirt and oxides from the surface of P-Ti and fully exposed the fresh titanium matrix to react with the hydrothermal solution. Because the interface is clean as well as micro-pitted, the hydrothermal SNW coatings are embedded with the substrate through the “rivet” effect, that is, the adhesive strength between the coating and substrate is further increased through mechanical embedment. Dong et al. [27] studied the downward/upward bidirectional cogrowth of approximately vertical titanate nanowire coatings on a Ti substrate in a NaOH solution, during which a corrosion region emerged on the Ti surface and grew downward, forming a dense base for titanate nanowires to root deep inside. Therefore, accompanied by the in situ downward growth of titanate nanowires, the cogrowth mechanism may lead to improved adhesive strength between the titanate coatings and the Ti substrate. Compared with the SNW, the critical load of the CNW is further increased, which can be attributed to the lattice distortion of the SNW caused by the replacement of Na+ by Cu2+ during IE, which increases the deformation resistance, leading to solid solution strengthening and thus increases the cohesion strength of the CNW. Therefore, the synergistic effect of the acid etching, bidirectional cogrowth, and solution-strengthening mechanisms can endow the coating with higher adhesive and cohesive strengths.
3.7. Cu2+ Release of the Coatings
Figure 7 shows the quantification of the Cu2+ ions released from the CNW coatings immersed in PS solutions for 1, 3, 7, 14, and 21 d. The Cu2+ concentrations in the PS solutions after immersing the coatings tended to increase sharply in the period of 0–7 d and then gradually stabilized (Figure 7a). All samples exhibited a sustained release of ions during the three weeks. Moreover, the surface and cross-sectional morphologies (Figure 7b,c) of the coatings immersed in PS for 21 d showed no changes compared to the non-immersed ones. These results suggest that the coatings have good structural stability. The Cu2+ ions substitute Na+ ions in the SNW and can be efficiently released from the lattice via exchange with Na+ ions from the solution rather than dissolution, endowing the coatings with superior long-term structural stability and bond strength. Over the prolonged immersion process, Cu2+ ions were initially rapidly released and then continuously at a low level. The cumulative release from 1 to 21 days is between 13.6 ± 0.5 and 22.3 ± 0.3 μM. According to the literature, Cu2+ ions do not damage mammalian cells within the concentration range of 10–100 μM [63,64,65], and they can simultaneously promote angiogenesis [30,31] and osteogenesis [32].

Figure 7.
(a) Cu2+ release kinetics from CNW coatings in PS solution for different immersion times and their (b) surface and (c) cross-sectional SEM images after immersion for 21 d.
3.8. Bactericidal Effects of the Coatings
The bactericidal effects of the coatings against adhesive S. aureus and E. coli were assessed by counting the bacterial colonies formed by dissociating them from the coated discs and re-cultivating them on agar, as shown in Figure 8. Compared to A-Ti, SNW/A-Ti and CNW/A-Ti exhibited antibacterial rates of 42.28 ± 3.7% and 69.13 ± 5.1% toward E. coli, respectively, and 42.71 ± 1.9% and 97.22 ± 1.4% toward S. aureus. Significantly fewer live bacteria were observed to adhere to SNW/A-Ti, indicating surface nanowire topography without additional contribution to bacterial adhesion, despite its higher surface roughness values compared to those of A-Ti. Furthermore, the number of viable bacteria decreased further for CNW/A-Ti, indicating pronounced bactericidal activity derived from the incorporation of Cu2+ ions. Cu2+ can damage respiratory enzymes by generating reactive oxygen species, and cause cell lysis, cytoplasm leakage, and bacterial death by extracting electrons from bacterial membranes [31,66]. The CNW coatings exhibited good antibacterial properties against Gram-positive and Gram-negative bacteria for localized antimicrobial delivery based on the continuous slow release of copper ions. These results suggest that coatings incorporated with bioactive Cu2+ ions may give rise to an advanced implant of improved clinical performance.
Figure 8.
Bacterial colonies on agar culture plates of (a–c) S. aureus and (d–f) E. coli cultured on various samples: (a,d) A-Ti, (b,e) SNW/A-Ti, and (c,f) CNW/A-Ti.
4. Discussion
The CNW coatings were grown hydrothermally on the surface of Ti disks where Cu2+ ions substituted Na+ in sodium titanate lattice and were efficiently released from the structure in a PS solution. Copper incorporation did not alter the micro-structure or phase components of the SNW coatings, ensuring superior long-term structural stability and bond strength. With the presence of released Cu2+ ions, the CNW-coated Ti disks (CNW/A-Ti) exhibited significant contact killing activity against S. aureus and E. coli. Therefore, this successful development presents a novel coating design that combines good adhesion strengths to Ti substrates with localized antimicrobial delivery and shape-preserving characteristics for achieving topographic, hydrophilic, and antibacterial activation of metal implants without dissolution. Although the reliability and chemical stability of CNW coatings in living organisms still need further experimental verification, the strategy described here provides valuable insights into the surface structural design of advanced multifunction bone implants for future applications in clinic.
Author Contributions
Conceptualization, Y.C., H.W. and Y.Z.; formal analysis, Y.C. and S.C.; investigation, Y.C., H.W., S.C., Z.L. and Y.Z.; methodology, Y.C. and Y.Z.; validation, S.C.; resources, H.W.; data curation, S.C. and Z.L.; writing—original draft preparation, Y.C., H.W., S.C., Z.L. and Y.Z.; writing—review and editing, Y.C., H.W., S.C., Z.L. and Y.Z.; visualization, Z.L.; software, Z.L.; supervision, H.W.; project administration, H.W.; funding acquisition, H.W. and Y.Z. All authors have read and agreed to the published version of the manuscript.
Funding
This research was funded by the National Natural Science Foundation of China, grant no. 51801158, the Nature Fund Project of Shandong Province, grant no. ZR2011EL003 and the Science and Technology benefiting the People Program of Weifang Hi-Tech Zone, grant no. 2019KJHM19.
Institutional Review Board Statement
Not applicable.
Informed Consent Statement
Not applicable.
Data Availability Statement
Data are contained within the article.
Acknowledgments
The authors are grateful for the Yuandu Scholar Program of Weifang (Advanced Film and Functional Coating Technology Research Positions).
Conflicts of Interest
The authors declare no conflicts of interest.
References
- Rammelt, S.; Illert, T.; Bierbaum, S.; Scharnweber, D.; Zwipp, H.; Schneiders, W. Coating of titanium implants with collagen, RGD peptide and chondroitin sulfate. Biomaterials 2006, 27, 5561–5571. [Google Scholar] [CrossRef] [PubMed]
- Zhang, L.; Webster, T.J. Nanotechnology and nanomaterials: Promises for improved tissue regeneration. Nano Today 2009, 4, 66–80. [Google Scholar] [CrossRef]
- Rani, V.V.; Vinoth-Kumar, L.; Anitha, V.C.; Manzoor, K.; Deepthy, M.; Shantikumar, V.N. Osteointegration of titanium implant is sensitive to specific nanostructure morphology. Acta Biomater. 2012, 8, 1976–1989. [Google Scholar] [CrossRef] [PubMed]
- Liu, X.; Lim, J.Y.; Donahue, H.J.; Dhurjati, R.; Mastro, A.M.; Vogler, E.A. Influence of substratum surface chemistry/energy and topography on the human fetal osteoblastic cell line hFOB 1.19: Phenotypic and genotypic responses observed in vitro. Biomaterials 2007, 28, 4535–4550. [Google Scholar] [CrossRef] [PubMed]
- Miron, R.J.; Oates, C.J.; Molenberg, A.; Dard, M.; Hamilton, D.W. The effect of enamel matrix proteins on the spreading, proliferation and differentiation of osteoblasts cultured on titanium surfaces. Biomaterials 2010, 31, 449–460. [Google Scholar] [CrossRef] [PubMed]
- Sugita, Y.; Ishizaki, K.; Iwasa, F.; Ueno, T.; Minamikawa, H.; Yamada, M.; Suzuki, T.; Ogawa, T. Effects of pico-to-nanometer-thin TiO2 coating on the biological properties of microroughened titanium. Biomaterials 2011, 32, 8374–8384. [Google Scholar] [CrossRef]
- Lim, J.Y.; Shaughnessy, M.C.; Zhou, Z.; Noh, H.; Vogler, E.A.; Donahue, H.J. Surface energy effects on osteoblast spatial growth and mineralization. Biomaterials 2008, 29, 1776–1784. [Google Scholar] [CrossRef]
- Setzer, B.; Bächle, M.; Metzger, M.C.; Kohal, R.J. The gene-expression and phenotypic response of hFOB 1.19 osteoblasts to surface-modified titanium and zirconia. Biomaterials 2009, 30, 979–990. [Google Scholar] [CrossRef] [PubMed]
- Dolatshahi-Pirouz, A.; Jensen, T.; Kraft, D.C.; Foss, M.; Kingshott, P.; Hansen, J.L.; Larsen, A.N.; Chevallier, J.; Besenbacher, F. Fibronectin adsorption, cell adhesion, and proliferation on nanostructured tantalum surfaces. ACS Nano 2010, 4, 2874–2882. [Google Scholar] [CrossRef]
- Heydarkhan-Hagvall, S.; Gluck, J.M.; Delman, C.; Jung, M.; Ehsani, N.; Full, S.; Shemin, R.J. The effect of vitronectin on the differentiation of embryonic stem cells in a 3D culture system. Biomaterials 2012, 33, 2032–2040. [Google Scholar] [CrossRef]
- Kuo, S.W.; Lin, H.I.; Ho, J.H.; Shih, Y.R.; Chen, H.F.; Yen, T.J.; Lee, O.K. Regulation of the fate of human mesenchymal stem cells by mechanical and stereo-topographical cues provided by silicon nanowires. Biomaterials 2012, 33, 5013–5022. [Google Scholar] [CrossRef] [PubMed]
- Liu, J.; Wang, X.; Jin, Q.; Jin, T.; Chang, S.; Zhang, Z.; Czajka-Jakubowska, A.; Giannobile, W.V.; Nör, J.E.; Clarkson, B.H. The stimulation of adipose-derived stem cell differentiation and mineralization by ordered rod-like fluorapatite coatings. Biomaterials 2012, 33, 5036–5046. [Google Scholar] [CrossRef] [PubMed]
- Okada, S.; Ito, H.; Nagai, A.; Komotori, J.; Imai, H. Adhesion of osteoblast-like cells on nanostructured hydroxyapatite. Acta Biomater. 2010, 6, 591–597. [Google Scholar] [CrossRef] [PubMed]
- Chelu, M.; Stroescu, H.; Anastasescu, M.; Calderon-Moreno, J.M.; Preda, S.; Stoica, M.; Fogarassy, Z.; Petrik, P.; Gheorghe, M.; Parvulescu, C.; et al. High-quality PMMA/ZnO NWs piezoelectric coating on rigid and flexible metallic substrates. Appl. Surf. Sci. 2020, 529, 147135. [Google Scholar] [CrossRef]
- Bavykin, D.; Walsh, F. Elongated Titanate Nanostructures and Their Applications. Eur. J. Inorg. Chem. 2009, 2009, 977–997. [Google Scholar] [CrossRef]
- Mark, K.; Park, J.; Bauer, S.; Schmuki, P. Nanoscale engineering of biomimetic surfaces: Cues from the extracellular matrix. Cell Tissue Res. 2010, 339, 131–153. [Google Scholar] [CrossRef] [PubMed]
- Park, J.K.; Kim, Y.J.; Yeom, J.; Jeon, J.H.; Yi, G.C.; Je, J.H.; Hahn, S.K. The topographic effect of zinc oxide nanoflowers on osteoblast growth and osseointegration. Adv. Mater. 2010, 22, 4857–4861. [Google Scholar] [CrossRef] [PubMed]
- Jang, J.H.; Castano, O.; Kim, H.W. Electrospun materials as potential platforms for bone tissue engineering. Adv. Drug Deliv. Rev. 2009, 61, 1065–1083. [Google Scholar] [CrossRef] [PubMed]
- Zhou, W.; Liu, H.; Boughton, R.I.; Du, G.; Lin, J.; Wang, J.; Liu, D. One-dimensional single-crystalline Ti–O based nanostructures: Properties, synthesis, modifications and applications. J. Mater. Chem. 2010, 20, 5993–6008. [Google Scholar] [CrossRef]
- Woo, K.M.; Chen, V.J.; Ma, P.X. Nano-fibrous scaffolding architecture selectively enhances protein adsorption contributing to cell attachment. J. Biomed. Mater. Res. Part A 2003, 67, 531–537. [Google Scholar] [CrossRef]
- Liu, X.; Chu, P.K.; Ding, C. Surface modification of titanium, titanium alloys, and related materials for biomedical applications. Mater. Sci. Eng. R Rep. 2004, 47, 49–121. [Google Scholar] [CrossRef]
- Huang, Y.; Ding, Q.; Pang, X.; Han, S.; Yan, Y. Corrosion behavior and biocompatibility of strontium and fluorine co-doped electrodeposited hydroxyapatite coatings. Appl. Surf. Sci. 2013, 282, 456–462. [Google Scholar] [CrossRef]
- Surmenev, R.; Surmeneva, M.; Ivanova, A. Significance of calcium phosphate coatings for the enhancement of new bone osteogenesis—A review. Acta Biomater. 2013, 10, 557–579. [Google Scholar] [CrossRef] [PubMed]
- Goyenvalle, E.; Aguado, E.; Nguyen, J.-M.; Passuti, N.; Le Guéhennec, L.; Layrolle, P.; Daculsi, G. Osteointegration of femoral stem prostheses with a bilayered calcium phosphate coating. Biomaterials 2006, 27, 1119–1128. [Google Scholar] [CrossRef] [PubMed]
- Yang, H.; Yu, M.; Wang, R.; Li, B.; Zhao, X.; Hao, Y.; Guo, Z.; Han, Y. Hydrothermally grown TiO2-nanorods on surface mechanical attrition treated Ti: Improved corrosion fatigue and osteogenesis. Acta Biomater. 2020, 116, 400–414. [Google Scholar] [CrossRef]
- Zhang, Y.; Han, Y.; Zhang, L. Formation and Bioactivity of SrTiO3 Nanotubes on Titanium by Modified Anodization and Hydrothermal Treatment. J. Mater. Sci. Technol. 2016, 32, 930–936. [Google Scholar] [CrossRef]
- Dong, W.; Zhang, T.; Epstein, J.; Cooney, L.; Wang, H.; Li, Y.; Jiang, Y.-B.; Cogbill, A.; Varadan, V.; Tian, Z.R. Multifunctional Nanowire Bioscaffolds on Titanium. Chem. Mater. 2007, 19, 4454–4459. [Google Scholar] [CrossRef]
- Park, J.Y.; Davies, J.E. Red blood cell and platelet interactions with titanium implant surfaces. Clin. Oral Implants Res. 2000, 11, 530–539. [Google Scholar] [CrossRef] [PubMed]
- Yao, X.; Zhang, X.; Wu, H.; Tian, L.; Ma, Y.; Tang, B. Microstructure and antibacterial properties of Cu-doped TiO2 coating on titanium by micro-arc oxidation. Appl. Surf. Sci. 2014, 292, 944–947. [Google Scholar] [CrossRef]
- Finney, L.; Vogt, S.; Fukai, T.; Glesne, D. Copper and Angiogenesis: Unravelling a Relationship Key to Cancer Progression. Clin. Exp. Pharmacol. Physiol. 2009, 36, 88–94. [Google Scholar] [CrossRef]
- Wu, Q.; Li, J.; Zhang, W.; Qian, H.; She, W.; Pan, H.; Wen, J.; Zhang, X.; Liu, X.; Jiang, X. Antibacterial property, angiogenic and osteogenic activity of Cu-incorporated TiO2 coating. J. Mater. Chem. B 2014, 2, 6738–6748. [Google Scholar] [CrossRef] [PubMed]
- Heidenau, F.; Mittelmeier, W.; Detsch, R.; Haenle, M.; Stenzel, F.; Ziegler, G.; Gollwitzer, H. A novel antibacterial titania coating: Metal ion toxicity and in vitro surface colonization. J. Mater. Sci. 2005, 16, 883–888. [Google Scholar] [CrossRef] [PubMed]
- Mirastschijski, U.; Martin, A.; Jorgensen, L.N.; Sampson, B.; Ågren, M.S. Zinc, copper, and selenium tissue levels and their relation to subcutaneous abscess, minor surgery, and wound healing in humans. Biol. Trace Elem. Res. 2013, 153, 76–83. [Google Scholar] [CrossRef] [PubMed]
- Sen, C.K.; Khanna, S.; Venojarvi, M.; Trikha, P.; Ellison, E.C.; Hunt, T.K.; Roy, S. Copper-induced vascular endothelial growth factor expression and wound healing. Am. J. Physiol. Heart Circ. Physiol. 2002, 282, H1821–H1827. [Google Scholar] [CrossRef] [PubMed]
- Zhang, L.; Guo, J.; Huang, X.; Zhang, Y.; Han, Y. The dual function of Cu-doped TiO2 coatings on titanium for application in percutaneous implants. J. Mater. Chem. B 2016, 4, 3788–3800. [Google Scholar] [CrossRef] [PubMed]
- Macomber, L.; Imlay, J.A. The iron-sulfur clusters of dehydratases are primary intracellular targets of copper toxicity. Proc. Natl. Acad. Sci. USA 2009, 106, 8344–8349. [Google Scholar] [CrossRef] [PubMed]
- Li, B.; Han, Y.; Qi, K. Formation Mechanism, Degradation Behavior, and Cytocompatibility of a Nanorod-Shaped HA and Pore-Sealed MgO Bilayer Coating on Magnesium. ACS Appl. Mater. Interfaces 2014, 6, 20. [Google Scholar] [CrossRef]
- Ye, J.; Li, B.; Li, M.; Zheng, Y.; Wu, S.; Han, Y. Formation of a ZnO nanorods-patterned coating with strong bactericidal capability and quantitative evaluation of the contribution of nanorods-derived puncture and ROS-derived killing. Bioact. Mater. 2022, 11, 181–191. [Google Scholar] [CrossRef]
- Xue, Y.; Chen, J.; Ding, T.; Mao, M.; Zhu, S.; Zhou, J.; Zhang, L.; Han, Y. Building biointegration of Fe2O3–FeOOH coated titanium implant by regulating NIR irradiation in an infected model. Bioact. Mater. 2022, 8, 1–11. [Google Scholar] [CrossRef]
- Zhao, L.; Wang, H.; Huo, K.; Cui, L.; Zhang, W.; Ni, H.; Zhang, Y.; Wu, Z.; Chu, P.K. Antibacterial nano-structured titania coating incorporated with silver nanoparticles. Biomaterials 2011, 32, 5706–5716. [Google Scholar] [CrossRef]
- GB 4789.2—2010; Food Microbiological Examination: Aerobic Plate Count. Ministry of Health of the People’s Republic of China: Beijing, China, 2010.
- Han, G.; Liu, S.; Pan, Z.; Lin, Y.; Ding, S.; Li, L.; Luo, B.; Jiao, Y.; Zhou, C. Sulfonated chitosan and phosphorylated chitosan coated polylactide membrane by polydopamine-assisting for the growth and osteogenic differentiation of MC3T3-E1s. Carbohydr. Polym. 2020, 229, 115517. [Google Scholar] [CrossRef]
- Faia-Torres, A.B.; Guimond-Lischer, S.; Rottmar, M.; Charnley, M.; Goren, T.; Maniura-Weber, K.; Spencer, N.D.; Reis, R.L.; Textor, M.; Neves, N.M. Differential regulation of osteogenic differentiation of stem cells on surface roughness gradients. Biomaterials 2014, 35, 9023–9032. [Google Scholar] [CrossRef]
- Yeo, A.; Wong, W.J.; Khoo, H.H.; Teoh, S.H. Surface modification of PCL-TCP scaffolds improve interfacial mechanical interlock and enhance early bone formation: An in vitro and in vivo characterization. J. Biomed. Mater. Res. Part A 2010, 92, 311–321. [Google Scholar] [CrossRef] [PubMed]
- Das, K.; Bose, S.; Bandyopadhyay, A. Surface modifications and cell-materials interactions with anodized Ti. Acta Biomater. 2007, 3, 573–585. [Google Scholar] [CrossRef]
- Wadge, M.D.; McGuire, J.; Hanby, B.V.T.; Felfel, R.M.; Ahmed, I.; Grant, D.M. Tailoring the degradation rate of magnesium through biomedical nano-porous titanate coatings. J. Magnes. Alloys 2021, 9, 336–350. [Google Scholar] [CrossRef]
- Li, J.; Zhang, W.; Qiao, Y.; Zhu, H.; Jiang, X.; Liu, X.; Ding, C. Chemically regulated bioactive ion delivery platform on a titanium surface for sustained controlled release. J. Mater. Chem. B 2014, 2, 283–294. [Google Scholar] [CrossRef]
- Xu, K.; Chen, W.; Hu, Y.; Shen, X.; Xu, G.; Ran, Q.; Yu, Y.; Mu, C.; Cai, K. Influence of strontium ions incorporated into nanosheet-pore topographical titanium substrates on osteogenic differentiation of mesenchymal stem cells in vitro and on osseointegration in vivo. J. Mater. Chem. B 2016, 4, 4549–4564. [Google Scholar] [CrossRef] [PubMed]
- Atuchin, V.; Kesler, V.; Pervukhina, N.; Zhang, Z. Ti 2p and O 1s Core Levels and Chemical Bonding in Titanium-Bearing Oxides. J. Electron Spectrosc. Relat. Phenom. 2006, 152, 18–24. [Google Scholar] [CrossRef]
- Meng, X.-D.; Wang, D.-Z.; Liu, J.-H.; Zhang, S.-Y. Preparation and characterization of sodium titanate nanowires from brookite nanocrystallites. Mater. Res. Bull. 2004, 39, 2163–2170. [Google Scholar] [CrossRef]
- Jose, M.; Szymańska, K.; Szymański, K.; Moszyński, D.; Mozia, S. Effect of copper salts on the characteristics and antibacterial activity of Cu-modified titanate nanotubes. J. Environ. Chem. Eng. 2020, 8, 104550. [Google Scholar] [CrossRef]
- Izawa, H.; Kikkawa, S.; Koizumi, M. Ion exchange and dehydration of layered [sodium and potassium] titanates, Na2Ti3O7 and K2Ti4O9. J. Phys. Chem 1982, 86, 5023–5026. [Google Scholar] [CrossRef]
- Tengvall, P.; Elwing, H.; Lundström, I. Titanium gel made from metallic titanium and hydrogen peroxide. J. Colloid Interface Sci. 1989, 130, 405–413. [Google Scholar] [CrossRef]
- Lee, K.; Yoo, D. Large-Area Sodium Titanate Nanorods Formed On Titanium Surface Via NaOH Alkali Treatment. Arch. Metall. Mater. 2015, 60, 1371–1374. [Google Scholar] [CrossRef]
- Kim, H.M.; Miyaji, F.; Kokubo, T.; Nakamura, T. Effect of heat treatment on apatite-forming ability of Ti metal induced by alkali treatment. J. Mater. Sci. 1997, 8, 341–347. [Google Scholar] [CrossRef]
- Yada, M.; Inoue, Y.; Uota, M.; Torikai, T.; Watari, T.; Noda, I.; Hotokebuchi, T. Plate, Wire, Mesh, Microsphere, and Microtube Composed of Sodium Titanate Nanotubes on a Titanium Metal Template. Langmuir 2007, 23, 2815–2823. [Google Scholar] [CrossRef] [PubMed]
- Chi, B.; Victorio, E.; Jin, T. Synthesis of TiO2-Based Nanotube on Ti Substrate by Hydrothermal Treatment. J. Nanosci. Nanotechnol. 2007, 7, 668–672. [Google Scholar] [CrossRef]
- Umek, P.; Korosec, R.C.; Jancar, B.; Dominko, R.; Arcon, D. The influence of the reaction temperature on the morphology of sodium titanate 1D nanostructures and their thermal stability. J. Nanosci. Nanotechnol. 2007, 7, 3502–3508. [Google Scholar] [CrossRef] [PubMed]
- Wang, Y.; Du, G.; Liu, H.; Liu, D.; Qin, S.; Wang, N.; Hu, C.; Tao, X.; Jiao, J.; Wang, J.; et al. Nanostructured Sheets of Ti-O Nanobelts for Gas Sensing and Antibacterial Applications. Adv. Funct. Mater. 2008, 18, 1131–1137. [Google Scholar] [CrossRef]
- De Souza, G.B.; Lepienski, C.M.; Foerster, C.E.; Kuromoto, N.K.; Soares, P.; Ponte, H.d.A. Nanomechanical and nanotribological properties of bioactive titanium surfaces prepared by alkali treatment. J. Mech. Behav. Biomed. Mater. 2011, 4, 756–765. [Google Scholar] [CrossRef]
- Szesz, E.M.; de Souza, G.B.; Santos, E.; Kuromoto, N.K. Nanomechanical Properties of Bioactive Ti Surfaces Obtained by NaOH-Based Anodic Oxidation and Alkali Treatment. Key Eng. Mater. 2012, 493–494, 524–529. [Google Scholar] [CrossRef]
- Ho, W.F.; Lai, C.H.; Hsu, H.C.; Wu, S.C. Surface modification of a Ti-7.5Mo alloy using NaOH treatment and Bioglass coating. J. Mater. Sci. 2010, 21, 1479–1488. [Google Scholar] [CrossRef] [PubMed]
- Yu, D.; Li, B.; Yu, M.; Guo, S.; Guo, Z.; Han, Y. Cubic multi-ions-doped Na2TiO3 nanorod-like coatings: Structure-stable, highly efficient platform for ions-exchanged release to immunomodulatory promotion on vascularized bone apposition. Bioact. Mater. 2022, 18, 72–90. [Google Scholar] [CrossRef] [PubMed]
- Ning, C.; Wang, X.; Li, L.; Zhu, Y.; Li, M.; Yu, P.; Zhou, L.; Zhou, Z.; Chen, J.; Tan, G.; et al. Concentration ranges of antibacterial cations for showing the highest antibacterial efficacy but the least cytotoxicity against mammalian cells: Implications for a new antibacterial mechanism. Chem. Res. Toxicol. 2015, 28, 1815–1822. [Google Scholar] [CrossRef] [PubMed]
- Zhang, L.; Guo, J.; Yan, T.; Han, Y. Fibroblast responses and antibacterial activity of Cu and Zn co-doped TiO2 for percutaneous implants. Appl. Surf. Sci. 2018, 434, 633–642. [Google Scholar] [CrossRef]
- Wu, H.; Zhang, X.; Geng, Z.; Yin, Y.; Hang, R.; Huang, X.; Yao, X.; Tang, B. Preparation, antibacterial effects and corrosion resistant of porous Cu–TiO2 coatings. Appl. Surf. Sci. 2014, 308, 43–49. [Google Scholar] [CrossRef]
Disclaimer/Publisher’s Note: The statements, opinions and data contained in all publications are solely those of the individual author(s) and contributor(s) and not of MDPI and/or the editor(s). MDPI and/or the editor(s) disclaim responsibility for any injury to people or property resulting from any ideas, methods, instructions or products referred to in the content. |
© 2024 by the authors. Licensee MDPI, Basel, Switzerland. This article is an open access article distributed under the terms and conditions of the Creative Commons Attribution (CC BY) license (https://creativecommons.org/licenses/by/4.0/).